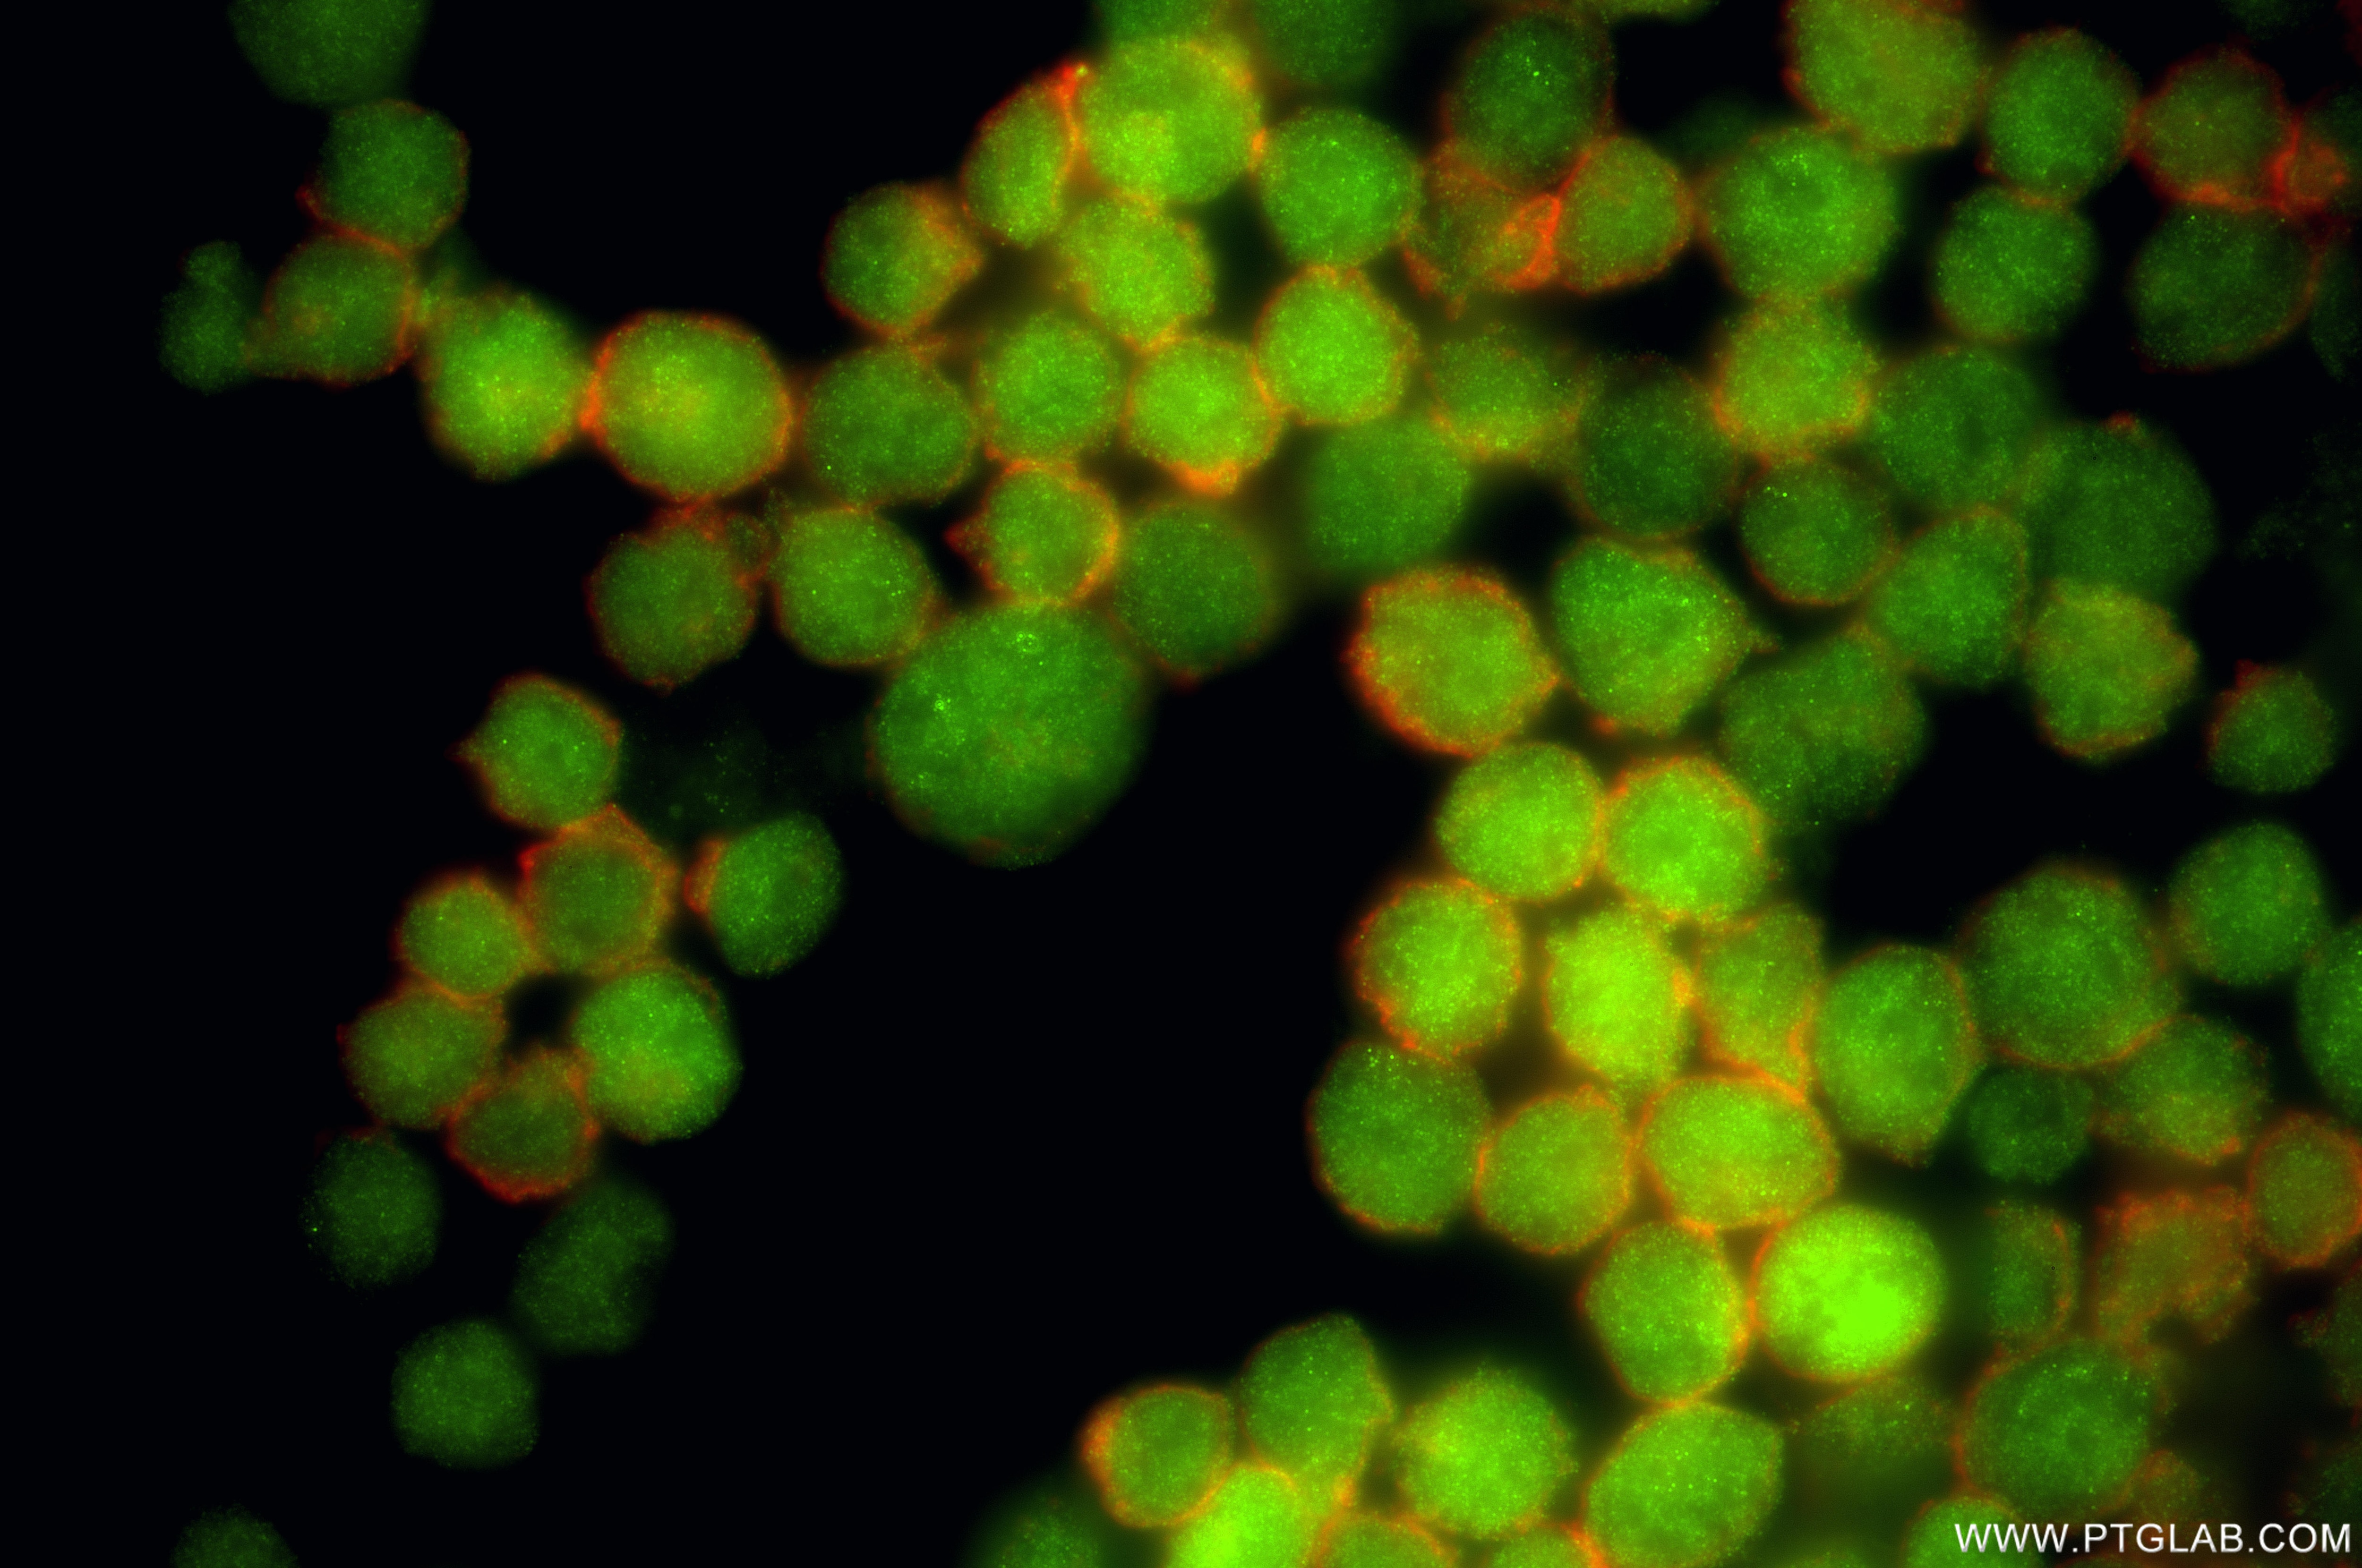
Immunofluorescence (IF) / fluorescent staining of K-562 cells using STAMBP Recombinant monoclonal antibody (86601-3-RR)

Tested Applications
| Positive WB detected in | A549 cells, NIH/3T3 cells, rat brain tissue, Jurkat cells, SW480 cells, K-562 cells, mouse brain tissue |
| Positive IF/ICC detected in | K-562 cells |
Recommended dilution
| Application | Dilution |
|---|---|
| Western Blot (WB) | WB : 1:5000-1:50000 |
| Immunofluorescence (IF)/ICC | IF/ICC : 1:50-1:500 |
| It is recommended that this reagent should be titrated in each testing system to obtain optimal results. | |
| Sample-dependent, Check data in validation data gallery. | |
Product Information
86601-3-RR targets STAMBP in WB, IF/ICC, ELISA applications and shows reactivity with human, mouse, rat samples.
| Tested Reactivity | human, mouse, rat |
| Host / Isotype | Rabbit / IgG |
| Class | Recombinant |
| Type | Antibody |
| Immunogen |
CatNo: Ag1895 Product name: Recombinant human STAMBP protein Source: e coli.-derived, PKG Tag: GST Domain: 124-424 aa of BC007682 Sequence: EKKKEAEELARNMAIQQELEKEKQRVAQQKQQQLEQEQFHAFEEMIRNQELEKERLKIVQEFGKVDPGLGGPLVPDLEKPSLDVFPTLTVSSIQPSDCHTTVRPAKPPVVDRSLKPGALSNSESIPTIDGLRHVVVPGRLCPQFLQLASANTARGVETCGILCGKLMRNEFTITHVLIPKQSAGSDYCNTENEEELFLIQDQQGLITLGWIHTHPTQTAFLSSVDLHTHCSYQMMLPESVAIVCSPKFQETGFFKLTDHGLEEISSCRQKGFHPHSKDPPLFCSCSHVTVVDRAVTITDLR Predict reactive species |
| Full Name | STAM binding protein |
| Calculated Molecular Weight | 48 kDa |
| Observed Molecular Weight | 48 kDa |
| GenBank Accession Number | BC007682 |
| Gene Symbol | STAMBP |
| Gene ID (NCBI) | 10617 |
| Conjugate | Unconjugated |
| Form | Liquid |
| Purification Method | Protein A purification |
| UNIPROT ID | O95630 |
| Storage Buffer | PBS with 0.02% sodium azide and 50% glycerol, pH 7.3. |
| Storage Conditions | Store at -20°C. Stable for one year after shipment. Aliquoting is unnecessary for -20oC storage. 20ul sizes contain 0.1% BSA. |
Background Information
STAM-binding protein (STAMBP) is also named AMSH. STAMBP, a member of the Jab1/MPN metalloenzyme family of deubiquitinating enzymes (DUBs), specifically cleaves K63-linked polyubiquitination chains from substrates (PMID: 15314065, PMID: 26601948). STAMBP is implicated in the endosome-lysosome pathway and shuttles ubiquitinated substrate proteins to lysosomes for degradation (PMID: 10383417, PMID: 24151880). STAMBP regulates protein degradation by binding to the ESCRT-0 protein STAM and the charged multivesicular body proteins of the ESCRT-III complex (PMID: 20159979). STAMBP is implicated in the inflammatory response by promoting the deubiquitination and stabilization of NALP7 and increasing the activity of inflammasomes (PMID: 28492230). STAMBP expression was increased in the cytoplasm of tumor cells from LUAD patients. STAMBP overexpression promoted cell migration and invasion, whereas STAMBP knockdown attenuated these processes in LUAD cells after epidermal growth factor treatment (PMID: 3410245).
Protocols
| Product Specific Protocols | |
|---|---|
| IF protocol for STAMBP antibody 86601-3-RR | Download protocol |
| WB protocol for STAMBP antibody 86601-3-RR | Download protocol |
| Standard Protocols | |
|---|---|
| Click here to view our Standard Protocols |